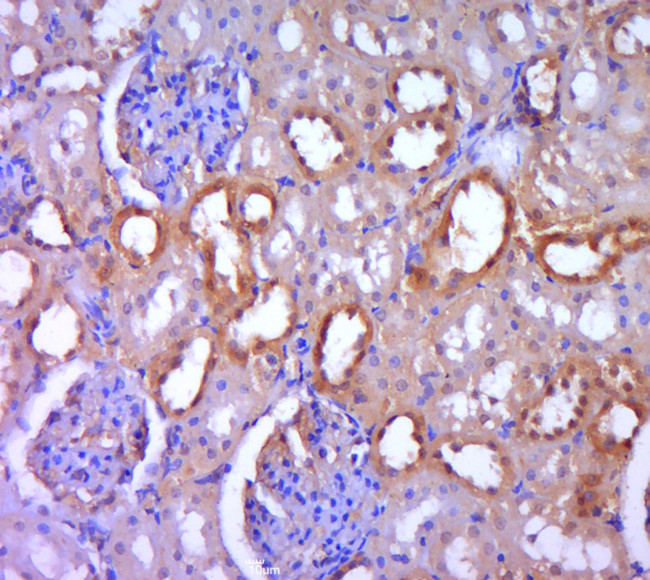
DGKH Antibody in Immunohistochemistry (Paraffin) (IHC (P))

Search
Bioss
DGKH Polyclonal Antibody
{{$productOrderCtrl.translations['antibody.pdp.commerceCard.promotion.promotions']}}
{{$productOrderCtrl.translations['antibody.pdp.commerceCard.promotion.viewpromo']}}
{{$productOrderCtrl.translations['antibody.pdp.commerceCard.promotion.promocode']}}: {{promo.promoCode}} {{promo.promoTitle}} {{promo.promoDescription}}. {{$productOrderCtrl.translations['antibody.pdp.commerceCard.promotion.learnmore']}}
图: 1 / 3
DGKH Antibody (BS-14298R) in IHC (P)



产品信息
BS-14298R
种属反应
宿主/亚型
分类
类型
抗原
偶联物
形式
浓度
规格
纯化类型
保存液
内含物
保存条件
运输条件
靶标信息
This gene encodes a member of the diacylglycerol kinase (DGK) enzyme family. Members of this family are involved in regulating intracellular concentrations of diacylglycerol and phosphatidic acid. Variation in this gene has been associated with bipolar disorder. Alternatively spliced transcript variants have been identified.
仅用于科研。不用于诊断过程。未经明确授权不得转售。
篇参考文献 (0)
生物信息学
蛋白别名: DAG kinase eta; DGK-eta; Diacylglycerol kinase eta; diacylglycerol kinase, eta; Diglyceride kinase eta; DKFZp761I1510; EC 2.7.1.107; unnamed protein product
基因别名: 5930402B05Rik; D130015C16; DGK; DGKeta; DGKH; RGD1561955
UniProt ID: (Human) Q86XP1, (Mouse) D3YXJ0
Entrez Gene ID: (Human) 160851, (Mouse) 380921, (Rat) 361076